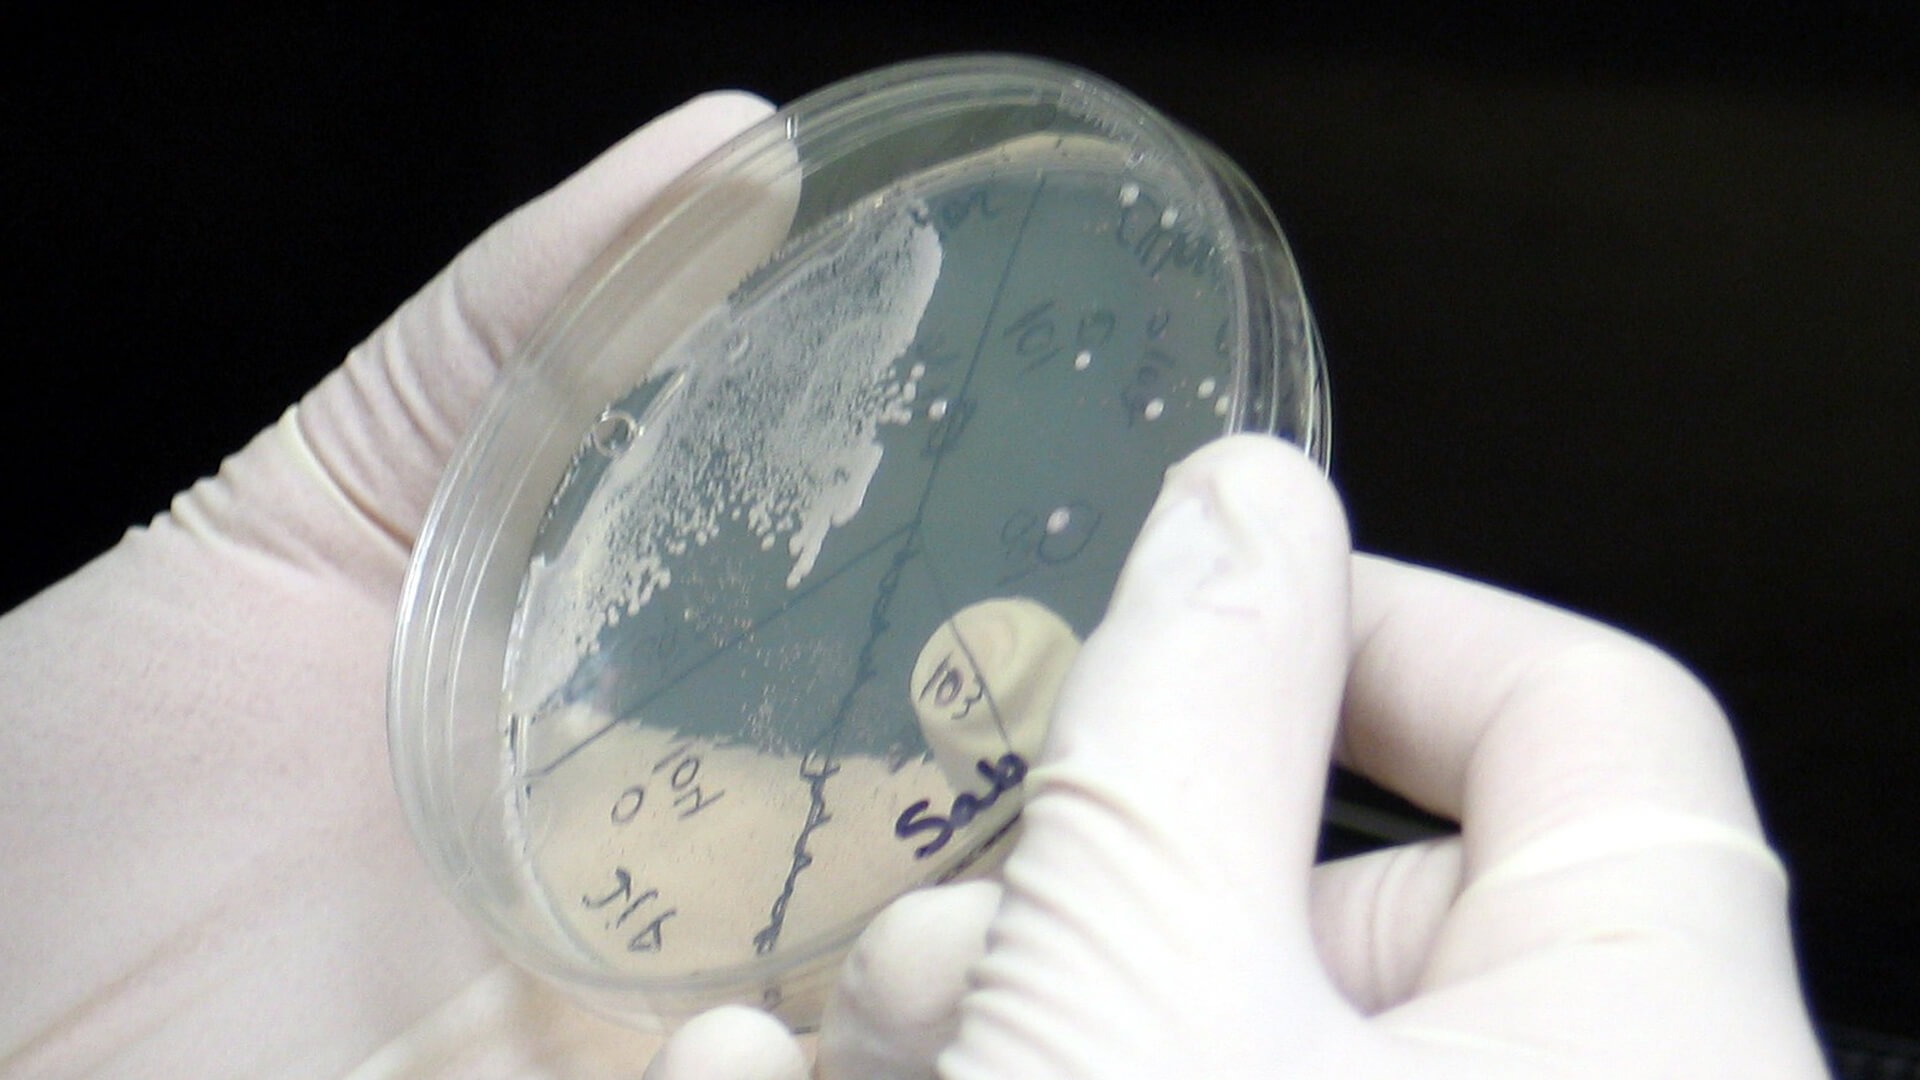

- Деси Балканска
- Грижа за косата, кожата и ноктите , Здраве и красота , Красота , Полезни съвети , Кожа, коса и нокти , Полезно
- 0 коментари
- Тагове: нокти, симптоми, лечение, гъбички, инфекция
Съдържание

Ноктите, както всяка друга част от тялото, са податливи на различни заболявания, най-често срещаното от които е онихомикозата, или иначе казано – гъбична инфекция. Тя може да засегне не само ноктите на краката, но и тези на ръцете. По-рискова зона обаче са стъпалата, тъй като обичайно те са поставени в условия на по-топла и по-влажна среда, каквато е тази в обувките. Ноктите на краката са по-податливи и на външни травми – при ходене, спорт или носене на по-тесни обувки, които възпрепятстват „дишането“ на краката и предизвикват по-обилно потене.
Как се проявява?
Онихомикозата се причинява от наличието и разпространението на дерматофитни гъбички, дрожди или плесени, които заразяват нокътя и го отслабват. Това състояние се проявява чрез различни видими промени в нокътя. Симптомите могат да варират в зависимост от вида на гъбичките и тежестта на инфекцията. Най-честите включват:
промени в цвета - засегнатите нокти могат да пожълтеят или по тях да се появят тебеширено бели люспи;
удебеляване - заразените нокти могат да станат по-дебели и по-трудни за рязане поради анормален растеж на нокътните клетки;
чупливост и лющене - ноктите с гъбички могат да станат чупливи и да се лющят лесно. Понякога изглеждат по-тънки или с неравни ръбове;
отделяне на нокътя - заразеният нокът може да се отдели от нокътното легло, което води до частично или пълно отделяне от кожата;
болка или дискомфорт - в по-тежки случаи може да се появи болка и дискомфорт при натиск върху нокътя по време на ходене или носене на тесни обувки.
Симптомите на онихомикозата могат да включват също неприятна миризма, парене и известен дискомфорт в засегнатата област.
Това заболяване е заразно, поради което е важно да се действа своевременно със специфични противогъбични средства, за да се предотврати по-нататъшен растеж на гъбичките и засягането на останалите нокти. Възрастните хора са по-податливи към онихомикоза поради забавен клетъчен обмен и намалено кръвообращение в крайниците. Засегнати могат да бъдат и децата, затова е важно редовно да преглеждате състоянието на ноктите им.
Какво го причинява?
Виновници за онихомикозата са дерматофитните гъбички (най-често щамовете Trichophyton, Microsporum и Epidermophyton), които обичайно съществуват в безвреден контакт с кожата и ноктите. В някои специфични ситуации обаче тези микроорганизми могат да навлязат в тялото чрез микролезии или пукнатини около нокътя или околната кожа и да започнат да се размножават неконтролируемо. Това води до инфекции, които могат да се предават чрез директен контакт на краката със заразени повърхности – например подове на обществени места като фитнес зали, басейни, душове или сауни.
Други причини и рискови фактори:
• продължително носене на тесни, затворени обувки, които не позволяват на краката да „дишат“;
• лоша лична хигиена;
• носене на чорапи, изработени от синтетични материали, които причиняват прекомерно изпотяване;
• травма или нараняване на ноктите, което може да създаде входна точка за гъбичките;
• прекомерно изпотяване (хиперхидроза) или продължително излагане на влага;
• лошо кръвообращение поради състояния като диабет или периферна съдова недостатъчност;
• имунодефицит или отслабена имунна система.
Диагнозата обикновено се поставя от дерматолог чрез визуален преглед на засегнатия нокът и, ако е необходимо, чрез вземане на проби за микологични изследвания.
Защо превенцията е важна?
Гъбичките по ноктите на краката не са лесна за лечение инфекция. Най-доброто лечение е именно превенцията – приемането на малки предпазни мерки и ежедневни практики, които намаляват риска от заразяване:
винаги поддържайте краката и ръцете си чисти, като ги миете старателно със сапун и вода и ги подсушавате внимателно, особено между пръстите;
носете памучни чорапи, които позволяват на краката да дишат;
избягвайте да носите твърде тесни обувки или такива с грешен размер за продължителен период от време, тъй като това насърчава натрупването на влага и може да доведе до триене и нараняване на ноктите;
не ходете боси в особено влажни общи помещения, като басейни, сауни или обществени съблекални, и винаги носете чехли, за да предпазите краката си;
не споделяйте обувки, кърпи или нокторезачки с други хора;
грижете се за ноктите на краката си, като ги режете редовно и ги поддържате чисти и с подходяща дължина.
Като следвате тези ежедневни практики, може значително да намалите риска от заразяване с гъбички по ноктите.

Работещи природни средства
В ранен етап онихомикозата е възможно да се повлияе и с някои натурални продукти. Такива са:
Ябълков оцет и водороден пероксид: Смесете 60 мл водороден пероксид (кислородна вода), 20 мл ябълков оцет и 2 с. л. 90-градусов спирт. Този разтвор може да се прилага директно върху заразените нокти. Съставките му имат противогъбични и антисептични свойства.
Етерично масло от лавандула: Нанасяйте директно върху нокътя два пъти дневно или разредете няколко капки във вана за крака заедно с лъжица сода бикарбонат.
Масло от чаено дърво: Едно от най-ефективните противогъбични и антибактериални масла. Използва се по същия начин като лавандуловото масло.
Сода бикарбонат: Полезно превантивно средство срещу гъбички по краката. Освен във вана за крака, може да се използва и като компрес, разтворена във вода.
Сол и лимон: Две вещества с дезинфекциращи свойства. Могат да се използват заедно или поотделно – директно върху засегнатото място или разтворени във вода за вана за крака.
Чесън: Съдържа алицин – съединение с изразен антимикробен ефект.
Ако подозирате, че имате гъбична инфекция на краката и не можете да се справите с помощта на тези природни средства, най-добре е да се консултирате с лекар или дерматолог. С ранна диагноза и подходящо лечение може ефективно да преборите инфекцията и да възстановите напълно външния вид и здравето на засегнатите нокти.
Съществуват различни медицински подходи за лечение на онихомикоза, включително лазерна терапия и хирургично отстраняване на заразения нокът. Изборът на лечение обаче зависи от лекаря, както и от формата и тежестта на състоянието. Обикновено се започва с противогъбични продукти за перорално приложение, локални средства (кремове или лосиони), противогъбични лакове за нокти и помощни вещества, ефективни срещу широк спектър от дерматофити, дрожди, плесени и други гъбички.
Онихомикозата често засяга големия пръст на крака, но може да се разпространи и към други пръсти или околната кожа (tinea pedis). Важно е да се отбележи, че инфекцията може да започне безсимптомно и да напредва бавно, което прави внимателното наблюдение на ноктите от съществено значение.
Източници:
https://www.mayoclinic.org/diseases-conditions/nail-fungus/diagnosis-treatment/drc-20353300
https://www.nhs.uk/conditions/fungal-nail-infection/
https://www.aad.org/public/diseases/a-z/nail-fungus-treatment
Свързани продукти
Масло за растеж на косата с розмарин – При изтъняване и слаби корени, 100 ml
Пшенична трева (диворастяща) – Енергия, детоксикация и грижа за кожата, 250 mg, 60 капсули
Арита на прах (плодове на сапунено дърво) – Натурален шампоан без сулфати, 100 g
Универсални мокри кърпички с лайка и алое, 80 бр.
Билкова маска за нокти на краката – При пожълтели и увредени нокти, 1 бр.
Универсална пилинг маска за крака – За гладки и хидратирани стъпала, 1 чифт
Интензивна пилинг маска за крака– При напукани пети и загрубяла кожа, 1 чифт
Морски колаген и глутатион – Против стареене и за сияен тен, 90 капсули
Масло за тяло с ашваганда – При стрес и напрежение, 118 ml
Масло за тяло с Арника – стави и мускули, 118 ml
Босвелия Серата етерично масло – Релаксация и фокус, 10 ml
Карамфил етерично масло – Антибактериално действие, 10 ml
Germ Fighter Organic етерични масла – Антибактериално действие, 10 ml етерично масло
Течни микроелементи Мед и Цинк – Силен имунитет и енергия, 20 ампули
Биотин – При косопад и чупливи нокти, 5000 µg, 120 желирани таблетки, горски плодове
Черен кимион (масло от семена) – При хронични възпаления и отслабен имунитет, 1000 mg,...
Крем за къдрици с масло от авокадо и хидролизирана коприна, 250 ml
Подхранващ крем с ланолин – За суха и напукана кожа, 10 g
Рициново масло – Стимулира растежа на косата, веждите и ноктите, 120 g
Формула за гъста и здрава коса с колагенови пептиди, билки и витамини – 90 капсули
Серум против прогресивен косопад – Без силикони, 100 ml
Маска за растеж и сгъстяване на косата – Без силикони, 200 ml
Серум за растеж и сгъстяване на косата – Без силикони, 100 ml
Гел за оформяне и фиксиране на къдрици – Без силикони, 250 ml
Подхранваща маска за къдрава коса – Без силикони, 200 ml
Подхранващ шампоан за къдрава коса – Без силикони и сулфати, 200 ml
Урукум Бикса (Анато) – Естествен загар и защита на кожата, 415 mg, 500 капсули
Крем с хвойнов катран – При проблемна кожа и раздразнения, 100 ml
Лигнани от лен 125 mg – Хормонален баланс, 60 капсули
Ленено масло – Сърце и холестерол, 400 ml
Моделираща лифтинг маска за брадичка V-Line, 1 бр.
Маска за чело с колаген – За изглаждане на бръчки, 1 брой, 3 x 15 см
Маска за лице с колаген и злато – За хидратация и анти-ейдж грижа, 1 брой, 17 x 21 см
Прочети още










Коментари (0)
Нов коментар